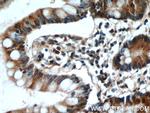
ITLN1 Antibody in Immunohistochemistry (Paraffin) (IHC (P))

Search
Proteintech
ITLN1 Polyclonal Antibody
{{$productOrderCtrl.translations['antibody.pdp.commerceCard.promotion.promotions']}}
{{$productOrderCtrl.translations['antibody.pdp.commerceCard.promotion.viewpromo']}}
{{$productOrderCtrl.translations['antibody.pdp.commerceCard.promotion.promocode']}}: {{promo.promoCode}} {{promo.promoTitle}} {{promo.promoDescription}}. {{$productOrderCtrl.translations['antibody.pdp.commerceCard.promotion.learnmore']}}
产品信息
11770-1-AP
种属反应
已发表种属
宿主/亚型
分类
类型
抗原
偶联物
形式
浓度
规格
纯化类型
保存液
内含物
保存条件
运输条件
产品详细信息
Immunogen sequence: MNQLSFLLF LIATTRGWST DEANTYFKEW TCSSSPSLPR SCKEIKDECP SAFDGLYFLR TENGVIYQTF CDMTSGGGGW TLVASVHEND MRGKCTVGDR WSSQQGSKAV YPEGDGNWAN YNTFGSAEAA TSDDYKNPGY YDIQAKDLGI WHVPNKSPMQ HWRNSSLLRY RTDTGFLQTL GHNLFGIYQK YPVKYGEGKC WTDNGPVIPV VYDFGDAQKT ASYYSPYGQR EFTAGFVQFR VFNNERAANA LCAGMRVTGC NTEHHCIGGG GYFPEASPQQ CGDFSGFDWS GYGTHVGYSS SREITEAAVL LFYR (1-313 aa encoded by BC020664)
靶标信息
ITLN1 has no effect on basal glucose uptake but enhances insulin-stimulated glucose uptake in adipocytes. ITLN1 increases AKT phosphorylation in the absence and presence of insulin. ITLN1 may play a role in the defense system against microorganisms. ITLN1 may specifically recognize carbohydrate chains of pathogens and bacterial components containing galactofuranosyl residues, in a calcium-dependent manner. ITLN1 may be involved in iron metabolism.
仅用于科研。不用于诊断过程。未经明确授权不得转售。
生物信息学
蛋白别名: calcium-dependent galactosyl-specific lectin; calcium-dependent galactosyl-specific lectin; LFR; HL-1; ITLN; hIntL; FLJ20022; Endothelial lectin HL-1; FLJ20022; Galactofuranose-binding lectin; intelectin 1 (galactofuranose binding); intelectin 1 (galactofuranose binding)-like; intelectin 2; intelectin 5; intelectin a; Intelectin-1; Intelectin-1a; Intestinal lactoferrin receptor; ITLN-1; ITLN1; Omentin; unnamed protein product
基因别名: hIntL; HL-1; HL1; INTL; ITLN; ITLN1; Itln1a; Itln2; Itln5; Itlna; LFR; omentin; UNQ640/PRO1270
UniProt ID: (Human) Q8WWA0, (Mouse) O88310
Entrez Gene ID: (Human) 55600, (Rat) 498284, (Mouse) 16429